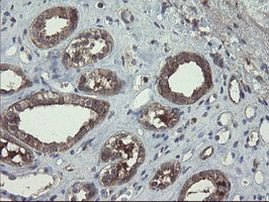
COMMD1 Antibody in Immunohistochemistry (Paraffin) (IHC (P))

Search
OriGene
COMMD1 Monoclonal Antibody (OTI3B3), TrueMAB™
{{$productOrderCtrl.translations['antibody.pdp.commerceCard.promotion.promotions']}}
{{$productOrderCtrl.translations['antibody.pdp.commerceCard.promotion.viewpromo']}}
{{$productOrderCtrl.translations['antibody.pdp.commerceCard.promotion.promocode']}}: {{promo.promoCode}} {{promo.promoTitle}} {{promo.promoDescription}}. {{$productOrderCtrl.translations['antibody.pdp.commerceCard.promotion.learnmore']}}
产品信息
CF504889
种属反应
宿主/亚型
分类
类型
克隆号
抗原
偶联物
形式
浓度
纯化类型
保存液
内含物
保存条件
运输条件
产品详细信息
For reconstitution, we recommend adding 100 µL distilled water to a final antibody concentration of about 1 mg/mL. To use this carrier-free antibody for conjugation experiments, we strongly recommend performing another round of desalting. (Zeba Spin Desalting Columns, 7KMWCO, 0.5 mL, Product # 89882)
靶标信息
Proposed scaffold protein that is implicated in diverse physiological processes and whose function may be in part linked to its ability to regulate ubiquitination of specific cellular proteins. Can modulate activity of cullin-RING E3 ubiquitin ligase (CRL) complexes by displacing CAND1; in vitro promotes CRL E3 activiy and dissocoiates CAND1 from CUL1 and CUL2. Promotes ubiquitination of NF-kappa-B subunit RELA and its subsequent proteasomal degradation. Down-regulates NF-kappa-B activity. Involved in the regulation of membrane expression and ubiquitination of SLC12A2. Modulates Na(+) transport in epithelial cells by regulation of apical cell surface expression of amiloride-sensitive sodium channel (ENaC) subunits and by promoting their ubiquitination presumably involving NEDD4L. Promotes the localization of SCNN1D to recycling endosomes. Promotes CFTR cell surface expression through regulation of its ubiquitination. Down-regulates SOD1 activity by interfering with its homodimerization. Plays a role in copper ion homeostasis. Involved in copper-dependent ATP7A trafficking between the trans- Golgi network and vesicles in the cell periphery; the function is proposed to depend on its association within the CCC complex and cooperation with the WASH complex on early endosomes. Can bind one copper ion per monomer. May function to facilitate biliary copper excretion within hepatocytes. Binds to phosphatidylinositol 4,5- bisphosphate (PtdIns(4,5)P2). Involved in the regulation of HIF1A-mediated transcription; competes with ARNT/Hif-1-beta for binding to HIF1A resulting in decreased DNA binding and impaired transcriptional activation by HIF-1.
仅用于科研。不用于诊断过程。未经明确授权不得转售。
篇参考文献 (0)
生物信息学
蛋白别名: COMM domain-containing protein 1; copper metabolism (Murr1) domain containing 1; copper metabolism gene MURR1; Protein Murr1
基因别名: C2orf5; COMMD1; MURR1
UniProt ID: (Human) Q8N668
Entrez Gene ID: (Human) 150684